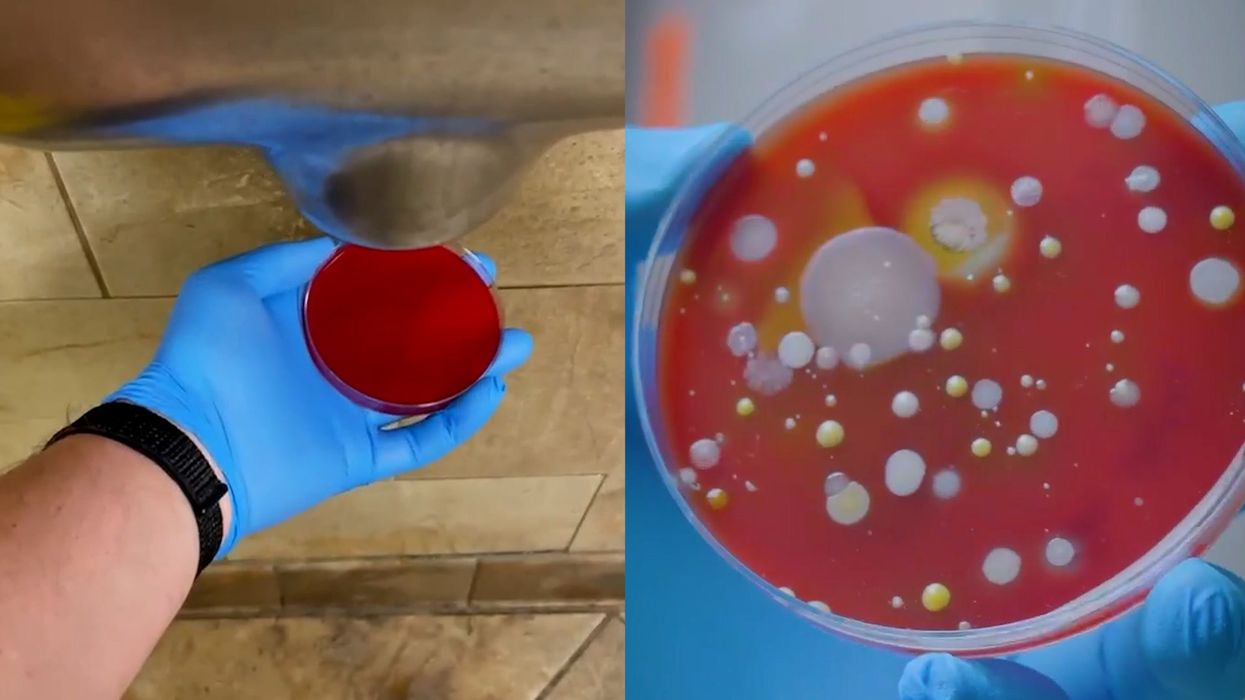

Science & Tech
Jake Brigstock
Nov 16, 2024
Experiment shows disgusting bacteria harboured by hand dryers
SWNS
There are a number of stories as to why hand dryers aren't exactly the most hygienic method of drying your hands after washing them and a scientist has proved why in a viral TikTok.
They are a much more eco-friendly way of drying your hands compared to paper towels and most public toilets across the UK use them.
But they may harbour more germs and bacteria than you may realise...
TikToker @devonscience, whose name is Ruth, regularly posts experiments on the social media platform and one in particular of her testing the germs spread by a hand dryer has gone viral.
Captioned "urghh, don't use a hand dryer 😱🦠", the viral video has 4.7m views at the time of writing along with 181k likes, 72k shares and thousands of comments.
@devonscience Urghh, don't use a hand dryer😱🦠----- Update: thank you for all your comments & suggestions. Totally blown away by how far this little video has reached 😮 I'm planning on doing some update videos on this experiment and will post on here, as well as on our FB & IG pages, which you are welcome to follow as well 😉 Thank you, Ruth (from Devon Science) #germs #publictoilet #bacteria #dirty #gross #justdont #scienceteacher #handwashchallenge #handdryer #science #scienceexperiments #microbiology #scienceproject #lesson #handdryer #handdryerbacteria
In the video, Ruth placed a Petri dish under a hand dryer that was blowing air out and she simply captured whatever it produced.
She also collected air from her laboratory in a separate Petri dish in the motion of waving her hands dry in the air and leaving them overnight before finding out what bacteria was in both the next day.
And the results were pretty concerning.
The hand dryer Petri dish showed different types of bacteria and fungus had grown, forming yellow spots, whereas the dish that was waved through the air was completely clear.
At the end of the video, Ruth said this is "why I don't use hand dryers" and showed herself drying her hands with paper towels.
If a hand dryer is the only option, it may be best to wave them in the air to partly dry them and then let them dry naturally instead, although it can take longer.
How to join the indy100's free WhatsApp channel
Sign up to our free indy100 weekly newsletter
Have your say in our news democracy. Click the upvote icon at the top of the page to help raise this article through the indy100 rankings.
Top 100
The Conversation (0)